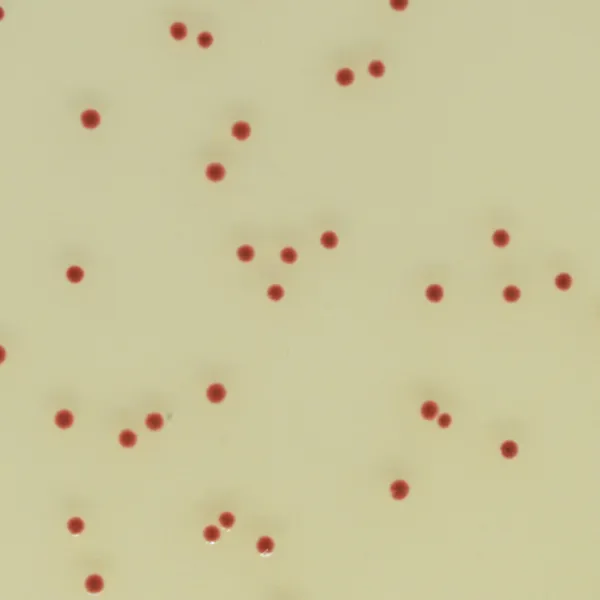
CHROMagar™ Campylobacter

Hình thái khuẩn lạc

Campylobacter jejuni, coli, lari
đỏ
Hiệu năng
Hiệu năng
Campylobacter là nguyên nhân chính gây ra bệnh tiêu chảy do thực phẩm ở người và là vi khuẩn phổ biến nhất gây viêm dạ dày-ruột trên toàn thế giới. Ở cả các nước phát triển và đang phát triển, chúng gây ra nhiều trường hợp tiêu chảy hơn Salmonella từ thực phẩm. Tỷ lệ mắc bệnh Campylobacter cao, cũng như thời gian kéo dài và sequelae có thể xảy ra của nó, làm cho nó trở nên quan trọng từ góc độ kinh tế xã hội. Ở các nước đang phát triển, nhiễm Campylobacter ở trẻ em dưới hai tuổi đặc biệt phổ biến, đôi khi dẫn đến tử vong.”
Tổ chức Y tế Thế giới (WHO) – Bảng thông tin N°255
Các loài Campylobacter là vi khuẩn yêu cầu cao, có thể khó phát hiện do điều kiện vận chuyển và/hoặc bảo quản mẫu không tối ưu và thiếu quy trình nuôi cấy thích hợp. Nhiều công thức môi trường nuôi cấy đã được phát triển, một số dựa trên máu, một số khác bao gồm than. Mỗi môi trường này đã cho thấy một sự thỏa hiệp trung bình giữa độ đặc hiệu và độ nhạy.
Mục đích sử dụng :
CHROMagar™ Campylobacter là môi trường nuôi cấy chromogen chọn lọc dùng để phát hiện trực tiếp định tính, phân biệt và nhận dạng sơ bộ Campylobacter chịu nhiệt. Xét nghiệm được thực hiện với mẫu phân hoặc phết trực tràng để hỗ trợ chẩn đoán nhiễm Campylobacter. Kết quả có thể được giải thích sau 36-48 giờ ủ vi hiếu khí ở 42 °C.
Cần có các nuôi cấy song song để phát hiện vi sinh vật cho các xét nghiệm vi sinh học tiếp theo hoặc định kiểu dịch tễ học.
Việc không có khuẩn lạc hoặc không xuất hiện khuẩn lạc trên CHROMagar™ Campylobacter không loại trừ sự hiện diện của Campylobacter.
CHROMagar™ Campylobacter không dùng để chẩn đoán nhiễm trùng hay để hướng dẫn hoặc theo dõi điều trị nhiễm trùng.
CHROMagar™ Campylobacter cũng có thể được sử dụng trong phát hiện Campylobacter trong phân tích các sản phẩm thực phẩm dùng cho người, thức ăn chăn nuôi và trong mẫu môi trường theo tiêu chuẩn ISO 10272-1.
1. Theo yêu cầu tiêu chuẩn ISO 10272-1 như là một môi trường chọn lọc để phát hiện Campylobacter.
4. Rất chọn lọc: Ngoài ra, độ chọn lọc cao làm cho đĩa rất sạch, ngay cả với các mẫu có vi hệ nặng nề.

2. Dễ đọc: 36-48 giờ ủ ở 42 °C. Màu đỏ đậm của khuẩn lạc trên nền thạch trong suốt giúp dễ đọc hơn so với môi trường thạch có than.
3. Tỷ lệ phục hồi cao: xấp xỉ 100 % Đếm Campylobacter chưa bao giờ dễ dàng và đáng tin cậy hơn thế.
Thành phần

Tài liệu kỹ thuật
Công bố khoa học
2023
EVALUACIÓN DEL DESEMPEÑO DIAGNÓSTICO DE MEDIOS DE CULTIVO CROMOGÉNICOS PARA EL AISLAMIENTO DE Campylobacterspp. EN MUESTRAS FECALES DE PACIENTES CON GASTROENTERITIS
? Publication2017
Comparison of four different selective media for the quantification of Campylobacter in poultry meat and rapid confirmation of suspect colonies
? Publication2017
Evaluation comparative de trois milieux de culture sélectifs: CHROMagar Campylobacter (CHROMagar), Karmali (Oxoid) et Campylosel (bioMérieux), pour la recherche des Campylobacter thermotolérants à partir des échantillons fécaux
? Publication2017
Evaluation of different Campylobacter jejuni isolates to colonize the intestinal tract of commercial turkey poults and selective media for enumeration
? Publication

Xem thêm